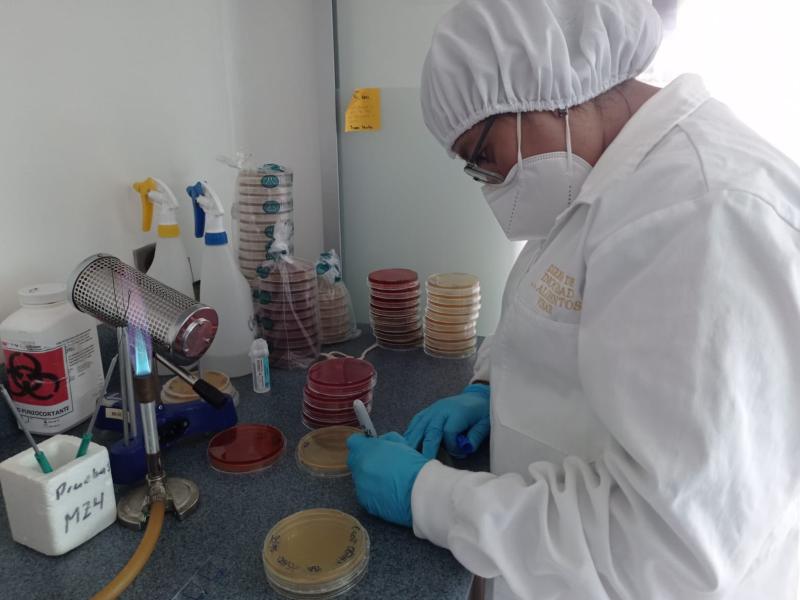

Laboratorio de Inocuidad garantiza calidad de los alimentos
Incluye
Los productos alimenticios que llegan a la mesa de la población deben cumplir con los estándares de calidad necesarios, por lo cual en el Laboratorio de Inocuidad del Ministerio de Agricultura, Ganadería y Alimentación (MAGA), que pertenece al Viceministerio de Sanidad Agropecuaria y Regulaciones (VISAR), se examinan distintos tipos de alimentos.
De enero a junio de 2024 fueron realizados 398 análisis en carnes de origen bovino, porcino y de aves, así como en frutas, hortalizas, granos básicos, entre otros productos alimenticios.
Con dichos procesos y servicios, la cartera de agricultura apoya a los productores y consumidores. Además, se asegura la inocuidad de los alimentos no procesados para consumo humano.
Datos del VISAR indican que en el referido laboratorio se cuenta con una capacidad para llevar a cabo análisis de patógenos como: Salmonella, E. coli. Asimismo, se pueden detectar residuos de medicamentos de uso veterinario en los alimentos.
Estas acciones se enmarcan en los objetivos estratégicos del MAGA, el cual refiere a la facilitación de servicios especializados para asegurar la producción de alimentos sanos e inocuos.